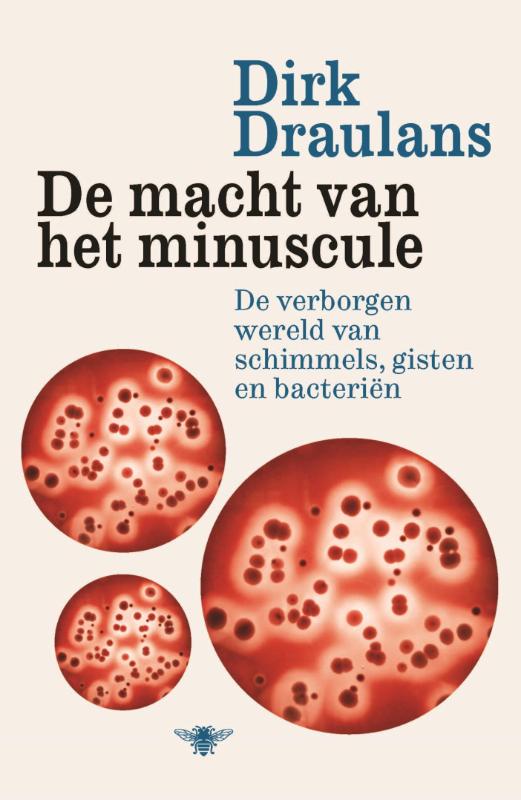
De macht van het minuscule

Het succes van slechte seks
hoe de evolutietheorie van toepassing is op elk van ons ( ja, ook op u)
Maak tweedehands je eerste keus
- Let op: door stakingen bij BPost in België kan je pakketje later komen.
- 30 dagen retourgarantie
- Gratis verzending vanaf 4 boeken of 40 euro
- Krijg van 21 tot en met 29 juni 10%, 15% of 25% korting per stapel.
- Van 21 tot en met 29 juni 4=3 actie op alles.
14,45
ISBN
9789085421603
Bindwijze
Paperback
Taal
Nederlands
Auteur
Uitgeverij
Standaard Uitgeverij t.b.v ISBN registratie
Jaar van uitgifte
2008
Aantal pagina's
480
Waar gaat het over?
Lees verder
Spijtig genoeg zijn er geen recensies over dit boek

Bachelor of ICT
nog 1 op voorraad
19,10

De bètacanon
Tweedehands
Echt gebruikt
6,00

Wereld In Je Binnenzak
25% korting
10,85
8,14

Thea stilton and the mystery on the orient express
Tweedehands
Als nieuw
16,65

Kogelvrije Veren
30% korting
5,45
3,81

Economic Complex Networks
nog 1 op voorraad
19,10